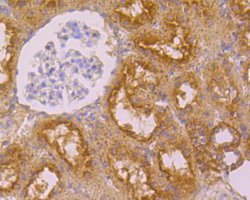

Promotional price valid on web orders only. Your contract pricing may differ. Interested in signing up for a dedicated account number?
Learn More
Learn More
Invitrogen™ Folate Receptor alpha Polyclonal Antibody


Rabbit Polyclonal Antibody
Supplier: Invitrogen™ PA5116453
Description
Positive controls: SKBR3 cell lysate, human placenta tissue lysate, human lung cancer tissue, human kidney tissue, mouse kidney tissue, rat kidney tissue.
The protein encoded by this gene is a member of the folate receptor family. Members of this gene family bind folic acid and its reduced derivatives, and transport 5-methyltetrahydrofolate into cells. This gene product is a secreted protein that either anchors to membranes via a glycosyl-phosphatidylinositol linkage or exists in a soluble form. Mutations in this gene have been associated with neurodegeneration due to cerebral folate transport deficiency. Due to the presence of two promoters, multiple transcription start sites, and alternative splicing, multiple transcript variants encoding the same protein have been found for this gene.
Specifications
| Folate Receptor alpha | |
| Polyclonal | |
| Unconjugated | |
| FOLR1 | |
| 66/67kDa; AA407891; adult folate-binding protein; eIF3 p66; EIF3D; eIF3d {ECO:0000255; eIF3p66; eIF3-p66; EIF3S7; eIF-3-zeta; eIF3-zeta; eIF-3-zeta {ECO:0000255; Eukaryotic translation initiation factor 3 subunit 7; eukaryotic translation initiation factor 3 subunit 7 {ECO:0000255; eukaryotic translation initiation factor 3 subunit D; eukaryotic translation initiation factor 3 subunit D {ECO:0000255; eukaryotic translation initiation factor 3, subunit 7 (zeta); eukaryotic translation initiation factor 3, subunit 7 zeta, 66/67kDa; eukaryotic translation initiation factor 3, subunit D; FBP; Fbp1; folate binding protein; folate binding protein 1; folate receptor 1; folate receptor 1 (adult); folate receptor alpha; Folate receptor, adult; folate-binding protein 1; Folbp1; Folbp-1; FOLR; FOLR1; FR-alpha; HAMAP-Rule:MF_03003}; KB cells FBP; MOv18; Ovarian tumor-associated antigen MOv18; translation initiation factor eIF3 p66; translation initiation factor eIF3 p66 subunit | |
| Rabbit | |
| Antigen affinity chromatography | |
| RUO | |
| 14275, 171049, 2348 | |
| Store at 4°C short term. For long term storage, store at -20°C, avoiding freeze/thaw cycles. | |
| Liquid |
| Immunohistochemistry (Paraffin), Western Blot, Western Blot | |
| 1 mg/mL | |
| PBS with 0.2% BSA, 50% glycerol and 0.05% sodium azide; pH 7.4 | |
| P15328, P35846 | |
| FOLR1 | |
| Recombinant protein within Human FOLR1 aa 25-257. | |
| 100 μL | |
| Primary | |
| Human, Mouse, Rat | |
| Antibody | |
| IgG |
Safety and Handling
WARNING: Cancer - www.P65Warnings.ca.gov
Product Content Correction
Your input is important to us. Please complete this form to provide feedback related to the content on this product.
Product Title
Spot an opportunity for improvement?Share a Content Correction